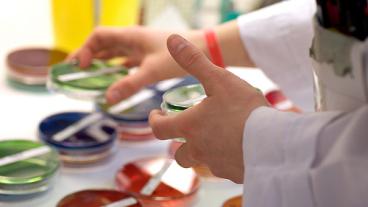
Foto: Jan Fredrik Frantzen

Fördjupning:
Senast uppdaterad: 30 november 2022
Mer fakta
Annonser

Politisk annons
Transparensmeddelande enligt EU-förordning (EU) 2024/900
Denna annons är politisk reklam producerad och betald av Socialdemokraterna i Europaparlamentet.
Postadress: Europaparlamentet, ASP 12 G 201, B-1047 Bryssel, Belgien
Kontaktperson: Per Hilmersson, kanslichef Socialdemokraterna i Europaparlamentet, per.hilmersson@europarl.europa.eu
Annonsen syftar till att väcka intresse för Facebooksidan från Socialdemokraterna i Europaparlamentet. Annonsutrymmet gäller för perioden 15 december 2025 – 14 december 2026 på Europaportalen.se till en kostnad av 89 515 kr.
Annonsen syftar till att väcka intresse för Facebooksidan från Socialdemokraterna i Europaparlamentet. Annonsutrymmet gäller för perioden 15 december 2025 – 14 december 2026 på Europaportalen.se till en kostnad av 89 515 kr.
Annonsen har finansierats av Progressiva förbundet av socialdemokrater i Europaparlamentet (S&D) , den partigrupp som Socialdemokraterna tillhör i Europaparlamentet. Inga medel från sponsorer utanför EU har använts för att bekosta denna annons.
Om du anser att detta meddelande inte uppfyller kraven i EU:s förordning om politisk reklam ska du i första hand kontakta red@europaportalen.se. Alternativt gör du en anmälan till Mediemyndigheten genom att använda den här e-tjänsten.
Om du anser att detta meddelande inte uppfyller kraven i EU:s förordning om politisk reklam ska du i första hand kontakta red@europaportalen.se. Alternativt gör du en anmälan till Mediemyndigheten genom att använda den här e-tjänsten.

Annonser

Politisk annons
Transparensmeddelande enligt EU-förordning (EU) 2024/900
Denna annons är politisk reklam producerad och betald av Socialdemokraterna i Europaparlamentet.
Postadress: Europaparlamentet, ASP 12 G 201, B-1047 Bryssel, Belgien
Kontaktperson: Per Hilmersson, kanslichef Socialdemokraterna i Europaparlamentet, per.hilmersson@europarl.europa.eu
Annonsen syftar till att väcka intresse för Facebooksidan från Socialdemokraterna i Europaparlamentet. Annonsutrymmet gäller för perioden 15 december 2025 – 14 december 2026 på Europaportalen.se till en kostnad av 89 515 kr.
Annonsen syftar till att väcka intresse för Facebooksidan från Socialdemokraterna i Europaparlamentet. Annonsutrymmet gäller för perioden 15 december 2025 – 14 december 2026 på Europaportalen.se till en kostnad av 89 515 kr.
Annonsen har finansierats av Progressiva förbundet av socialdemokrater i Europaparlamentet (S&D) , den partigrupp som Socialdemokraterna tillhör i Europaparlamentet. Inga medel från sponsorer utanför EU har använts för att bekosta denna annons.
Om du anser att detta meddelande inte uppfyller kraven i EU:s förordning om politisk reklam ska du i första hand kontakta red@europaportalen.se. Alternativt gör du en anmälan till Mediemyndigheten genom att använda den här e-tjänsten.
Om du anser att detta meddelande inte uppfyller kraven i EU:s förordning om politisk reklam ska du i första hand kontakta red@europaportalen.se. Alternativt gör du en anmälan till Mediemyndigheten genom att använda den här e-tjänsten.